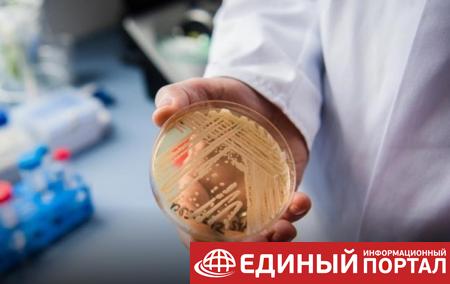

В США обнаружили очаг заражений опасным грибком
Candida auris – новый патоген, который может вызвать серьезные инфекции, особенно у людей с хроническими заболеваниями.
В американском штате Орегон впервые зафиксировали вспышку заражения опасным грибком Candida auris, который устойчивым к лекарственным средствам. Подтверждено три случая, сообщил накануне ресурс Beckers Hospital Review.
"Candida auris, смертельный, устойчивый к препаратам грибок, обнаруженный у трех пациентов из Сейлема, штат Орегон, что стало первым случаем инфекции в штате", – говорится в сообщении.
Известно, что первый случай заражения был обнаружен в больнице Сейлема 11 декабря. Второй и третий были зафиксированы 23 и 27 декабря.
"Candida auris – новый патоген, который вызывает беспокойство, потому что он может вызвать серьезные инфекции, особенно у людей с хроническими заболеваниями, и может быть устойчивым к противогрибковым препаратам", – говорится в сообщении.
Сейчас управление здравоохранения США работает с местными партнерами и CDC по расследованию этой вспышки.
По данным органов здравоохранения США, с 2013 года в стране было зарегистрировано более 1 150 клинических случаев Candida auris.
Напомним, нынешним летом в США выявили две вспышки заражения грибком Candida auris – в Вашингтоне и в Техасе заболели более 120 человек.
Впервые Candida auris был описан в 2009 году у пациента в Японии. Сейчас грибок идентифицирован на пяти континентах. Вспышка этого грибка произошла в больницах Великобритании в 2019 году – были заражены 200 пациентов, погибли восемь человек.
Читайте Korrespondent.net в Google News
Понравилась статья? Поделитесь ей с друзьями:
Рекомендуем похожее:
В Мексике первый случай заражения двумя COVID-штаммами одновременно
В Китае выявлен новый очаг заражения коронавирусом
В США выявили два очага заражения опасным грибком
В Китае всего два случая заражения коронавирусом за сутки
В США в 10 штатах зафиксировали вспышку кишечной инфекции
В России предупредили о случаях бубонной чумы в США
 Качественные автозапчасти для коммерческих моделей автомобилей — несколько причин обратиться в интернет-магазин «BUS-shop»
Качественные автозапчасти для коммерческих моделей автомобилей — несколько причин обратиться в интернет-магазин «BUS-shop»
 Ключевые особенности новостных сайтов
Ключевые особенности новостных сайтов
 Ключевые преимущества новостных сайтов
Ключевые преимущества новостных сайтов
 Австралия запретила продажу РФ компонентов для производства оружия
Австралия запретила продажу РФ компонентов для производства оружия
 Австралия предоставит Украине еще $15,5 млн военной помощи
Австралия предоставит Украине еще $15,5 млн военной помощи
 США предложили Турции передать Украине российские С-400 - Reuters
США предложили Турции передать Украине российские С-400 - Reuters
 Байден пригрозил КНР, если та станет помогать России
Байден пригрозил КНР, если та станет помогать России
 Boeing ввел запрет на использование самолетов грузоперевезчику РФ
Boeing ввел запрет на использование самолетов грузоперевезчику РФ
 Ситуация в Донбассе: последние новости от ополчения и сила интернет-вестей
Ситуация в Донбассе: последние новости от ополчения и сила интернет-вестей
 Ситуация в Донбассе: последние новости от ополчения и сила интернет-вестей
Ситуация в Донбассе: последние новости от ополчения и сила интернет-вестей
 Ситуация в Донбассе: последние новости от ополчения и сила интернет-вестей
Ситуация в Донбассе: последние новости от ополчения и сила интернет-вестей
 Удаленный доступ к рабочему столу: всё, что нужно знать
Удаленный доступ к рабочему столу: всё, что нужно знать
 Удаленный доступ к рабочему столу: всё, что нужно знать
Удаленный доступ к рабочему столу: всё, что нужно знать

Добавить комментарий!